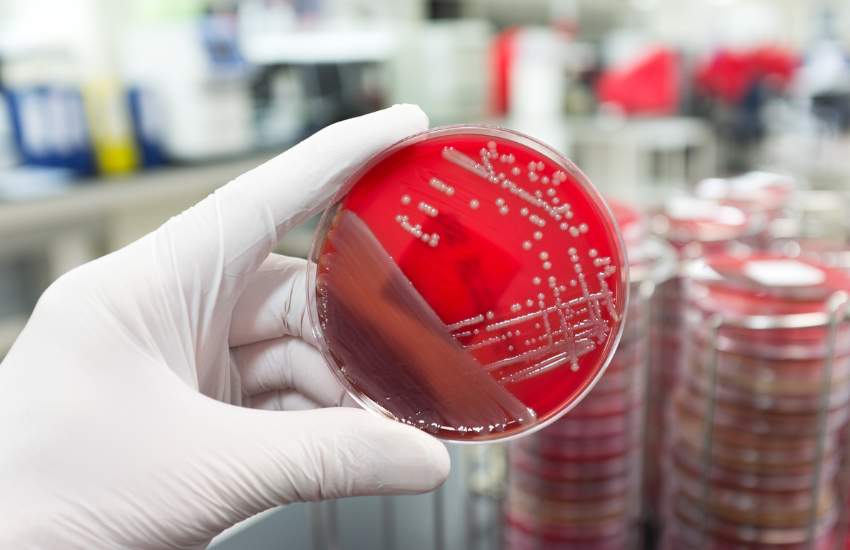

Healthy Heart CPR & First Aid is a certified training provider committed to equipping individuals, healthcare professionals, and organizations with the lifesaving skills and knowledge necessary to respond confidently in emergency situations. Our programs are designed to meet both community needs and professional certification requirements.
Certified CPR & First Aid Training in Denver, Colorado
Learn lifesaving skills with certified instructors. CPR, BLS, First Aid & AED training available for individuals, healthcare professionals, and organizations.
Healthy Heart (CPR & First Aid)
Our CPR & First Aid Training Programs
Choose from a wide range of courses designed to meet community needs and professional requirements:

CPR Training
A hands-on course that teaches lifesaving CPR skills for adults, children, and infants. Perfect for anyone who wants to be prepared for emergency situations.

First Aid Certification
Covers essential first aid skills, including wound care, choking response, and medical emergencies, designed for workplaces and community members.

Heartsaver CPR AED
Designed for non-medical individuals, this course teaches the basics of CPR and how to use an AED effectively during cardiac emergencies.

BLS for Healthcare Providers
A certification course for medical professionals focusing on high-quality CPR, AED use, and team-based response in clinical settings.

Heartsaver Pediatric First Aid CPR AED
Focused on childcare providers, teachers, and parents, this course covers pediatric emergencies including choking, CPR, and AED use for infants and children.
Bloodborne Pathogens Training
Bloodborne Pathogens Training Provides knowledge on how to protect yourself and others from bloodborne pathogens in workplace or community environments.
Who Can Benefit from Our Training
Our CPR and First Aid courses are designed to make both individuals and organizations safer, better prepared, and more confident in emergencies. Many industries and community services rely on our certified training to meet compliance requirements and ensure workplace safety, including:
- Firefighters & First Responders
- EMTs & Paramedics
- Teachers & Education Staff
- Childcare Providers
- Healthcare Workers & Caregivers
- Town & Municipal Services
- Government Employees
- Construction & Industrial Workers
- Restaurant & Hospitality Staff
- Commercial & Corporate Teams
Whether you are a professional required to maintain certification or simply want to be prepared for unexpected emergencies, our courses are designed to fit your needs.
Group & Workplace Training
Onsite Training for Denver Businesses, Schools & Organizations
From small businesses to large corporations, schools, and community groups, we provide convenient onsite CPR and First Aid training across Denver. Our corporate and group training sessions help organizations meet safety compliance standards while ensuring staff are prepared to respond to emergencies. Whether you need CPR, First Aid, AED, or OSHA-aligned Bloodborne Pathogens training, we will bring certified instructors to your location.
- Request Group Training
- +123-55-05800
Check What Our Client Say About Us
“ when an unknown printer took a galley of type and scrambled it to make a type specimen book. It has survived not only five centuries.”

Steven Sjones
“ Bookan unknown printer took a galley of type and scrambled make It has survivednot rinter took a galley of type and scrambled make ”

Mrs Rebeka
“ when an unknown printer took a galley of type and scrambled it to make a type specimen book. It has survived not only five centuries.”

Robert Smith
Frequently Asked Questions
Most CPR, First Aid, and BLS certifications are valid for two years. Renewal is required to stay updated with current standards.
Yes. We offer renewal courses designed to refresh your knowledge and skills in less time while meeting updated guidelines.
Yes. We regularly provide onsite training sessions for businesses, schools, and organizations across Denver and nearby areas.
Everyone can benefit from CPR training. Parents, teachers, coaches, caregivers, and healthcare professionals are strongly encouraged to learn these skills.
Yes. Upon successful completion, you’ll receive an official certification card valid for two years.
Most standard classes are 2–4 hours. Professional courses like BLS can take longer depending on requirements.
Yes. All our certifications meet national standards and are widely accepted across the U.S.
Yes. Our Heartsaver Pediatric course is designed for childcare providers, parents, and teachers.
